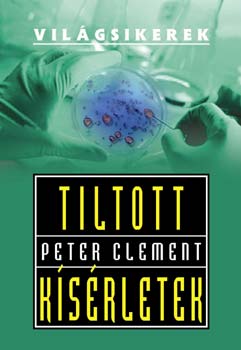
Peter Clement - Tiltott ksrletek

Könyv - Krimi, bűnügyi, thriller
0 | pécsi direkt kft. | 2006
A Pirkadat Kör titkos szövetség, amely ördögi terv végrehajtására kötelezi el magát:...
Szállítási idő:
4-6 munkanap
199 pontot ér
0 | m & c kft. | 2006
A maffia nem ismer kegyelmet. Senki sem szállhat szembe a világ legfélelmetesebb...
Szállítási idő:
4-6 munkanap
889 pontot ér
0 | gabo kiadó | 2006
Melis Nemid veszélyes vizeken hajózik és valakinek minden vágya, hogy lerántsa a mélybe...
Szállítási idő:
4-6 munkanap
99 pontot ér
0 | jlx kiadó | 2006
Büntetése letöltését követően békésen éli hétköznapjait egy connecticuti kisvárosban...
Szállítási idő:
6-8 munkanap
110 pontot ér
0 | k.u.k. kiadó | 2006
A 32 éves Mukhtar Mai Meerwalában él, Pakisztán középső részén, egy kis faluban. Törzsi...
Szállítási idő:
6-8 munkanap
94 pontot ér
0 | illia & co. kiadó | 2006
Szállítási idő:
6-8 munkanap
2399 pontot ér
0 | ismeretlen | 2006
23 ar gamle Willie Traynor kjopte den konkurstruede lokale ukeavisen The Ford County Times i...
Szállítási idő:
4-6 munkanap
379 pontot ér
0 | reader's digest kiadó kft. | 2006
A gyilkolóművész: Az oknyomozó riporterként dolgozó Alex Callahan már nem él együtt...
Szállítási idő:
4-6 munkanap
159 pontot ér
0 | m & c marketing tanácsadó kft. | 2006
Egy halott férj és egy kereken egymillió dollárt érő jade-szobor. Columbo hadnagy ismét az...
Szállítási idő:
4-6 munkanap
399 pontot ér
0 | reader's digest válogatás | 2006
Szállítási idő:
4-6 munkanap
94 pontot ér
0 | m & c marketing tanácsadó kft. | 2006
FÜLSZÖVEG A maffia nem ismer kegyelmet. Senki sem szállhat szembe a világ egyik...
Szállítási idő:
4-6 munkanap
479 pontot ér
0 | alexandra kiadó | 2006
A haditengerészeti techno-thrillerek nagymestereként számon tartott P. Robinson legújabb...
Szállítási idő:
4-6 munkanap
94 pontot ér
0 | radnai kiadó | 2006
Szállítási idő:
6-8 munkanap
189 pontot ér
0 | reader's digest kiadó kft. | 2006
Szállítási idő:
4-6 munkanap
94 pontot ér
0 | alexandra kiadó | 2006
Lezuhan az Oceanic 815-ös járata. A katasztrófának 48 túlélője van, akik egy szigeten érnek...
Szállítási idő:
4-6 munkanap
94 pontot ér
0 | general press kiadó | 2006
Bűntények sora, feszültség, sodró cselekmény, emberi drámák kell ennél több egy izgalmas...
Szállítási idő:
6-8 munkanap
94 pontot ér
0 | pallas antikvárium | 2006
Ha két ember ugyanazt akarja, ám szinte törvényszerűen mindig másképp, elkerülhetetlenek az...
Szállítási idő:
4-6 munkanap
94 pontot ér
0 | radnai kiadó | 2006
Dr. Patrick Graham sebész kevés szabadidejét szívesen töltötte hivatásától eltérő...
Szállítási idő:
4-6 munkanap
94 pontot ér
0 | gesta kiadó | 2006
Leslie L. Lawrence ezúttal Montserrat szigetére utazik, hogy elkísérje Siskin nagymestert egy...
Szállítási idő:
4-6 munkanap
169 pontot ér
0 | budapest | 2006
KÉPGARANCIA - Saját kép Író/Szerző: Nan Lyons; Ivan Lyons Fordító: Komáromy...
Szállítási idő:
6-8 munkanap
94 pontot ér